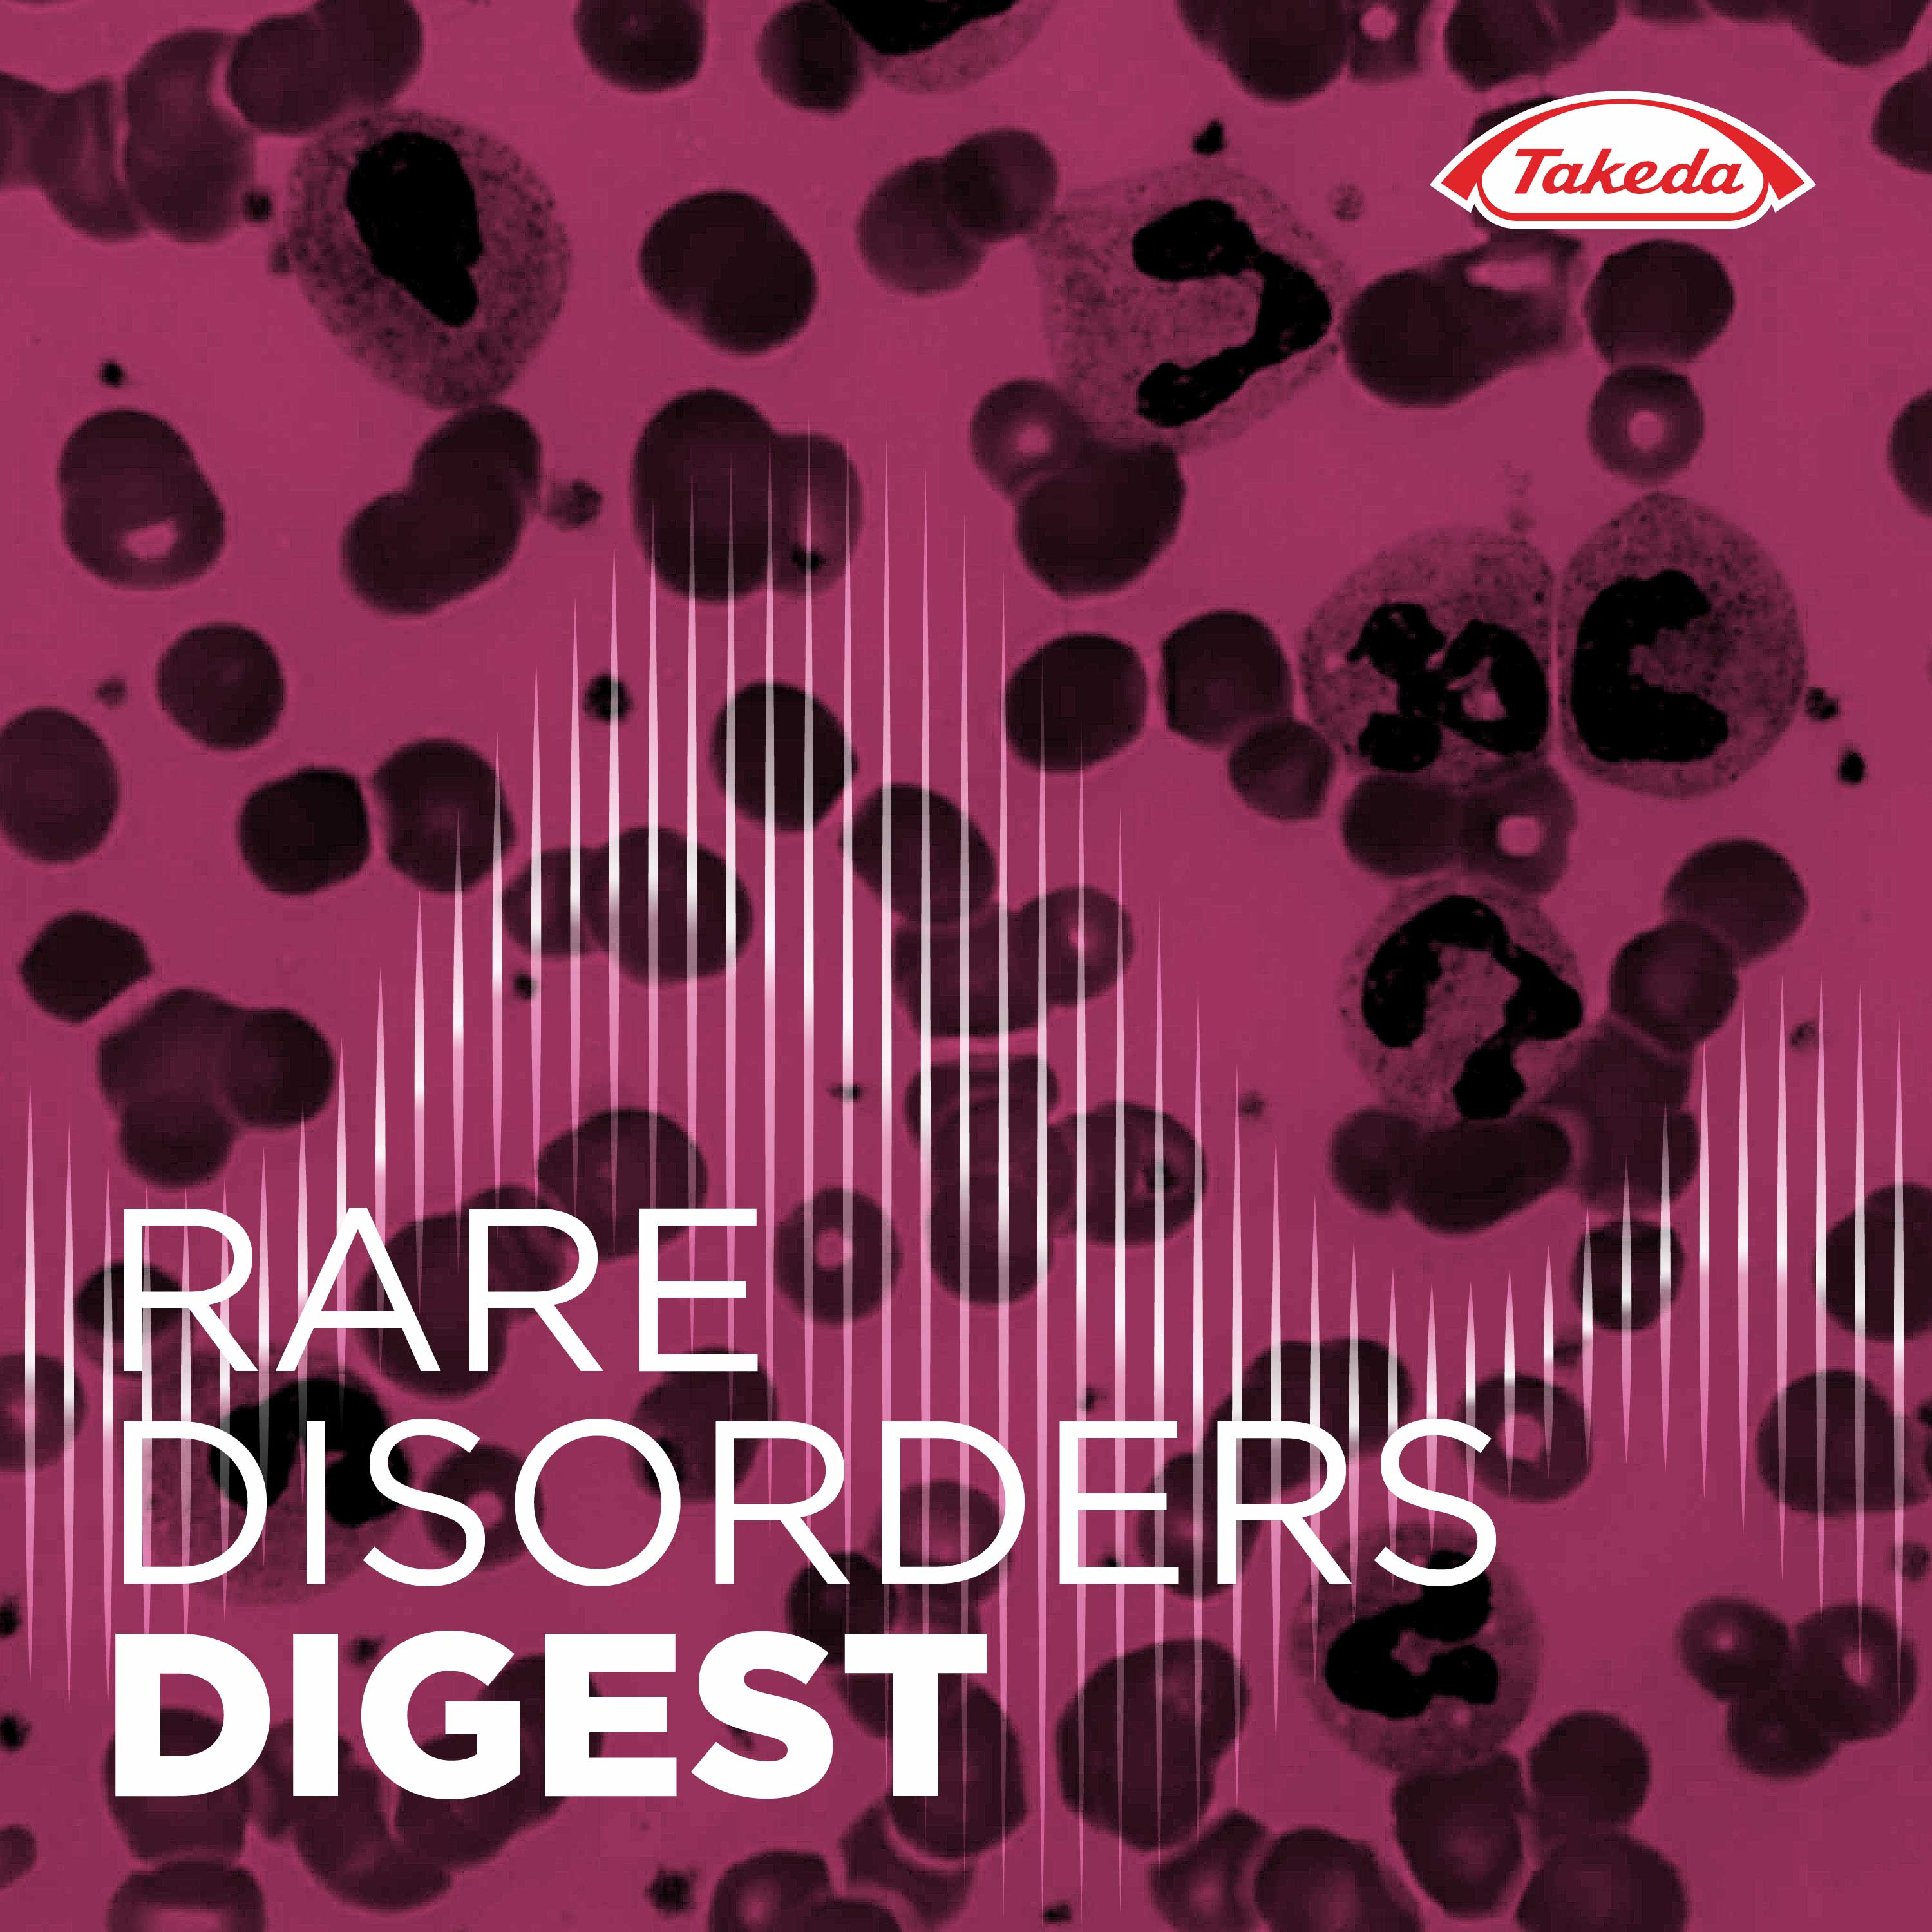

Rare Disorders Digest
Rare Disorders Digest is a Takeda podcast series designed to inform the audience about different rare diseases, and help them understand current diagnostic and treatment modalities, and some of the challenges that clinicians and patients face today. Listeners will hear from medical experts and patient advocates as they share their insights into current care and describe their aspirations for the …Social links:
Follow the podcast:



11 clip(s)
- 1
 Episode 1 – Living with Thrombotic Thrombocytopenic Purpura (TTP)10:41
Episode 1 – Living with Thrombotic Thrombocytopenic Purpura (TTP)10:41 - 2
 Episode 2 – Diagnosis of TTP03:17
Episode 2 – Diagnosis of TTP03:17 - 3
 Episode 3 – Treatment of TTP04:06
Episode 3 – Treatment of TTP04:06 - 4
Episode 4 – Case Studies08:03
Episode 4 – Case Studies08:03 - 5
 Episode 1 – Living with Dravet Syndrome (DS) and Lennox-Gastaut Syndrome (LGS)13:33
Episode 1 – Living with Dravet Syndrome (DS) and Lennox-Gastaut Syndrome (LGS)13:33 - 6
 Episode 2 – Diagnosis and treatment of DS14:14
Episode 2 – Diagnosis and treatment of DS14:14 - 7
 Episode 3 – Diagnosis and treatment of LGS12:19
Episode 3 – Diagnosis and treatment of LGS12:19 - 8
 Episode 4 – Case Studies16:31
Episode 4 – Case Studies16:31 - 9
 Episode 1 - Living with a lifelong Cytomegalovirus (CMV) infection08:20
Episode 1 - Living with a lifelong Cytomegalovirus (CMV) infection08:20 - 10
 Episode 2 – Diagnosis and Treatment of Post-Transplant CMV infection06:15
Episode 2 – Diagnosis and Treatment of Post-Transplant CMV infection06:15 - View more clips
 Rare Disorders Digest
Rare Disorders Digest